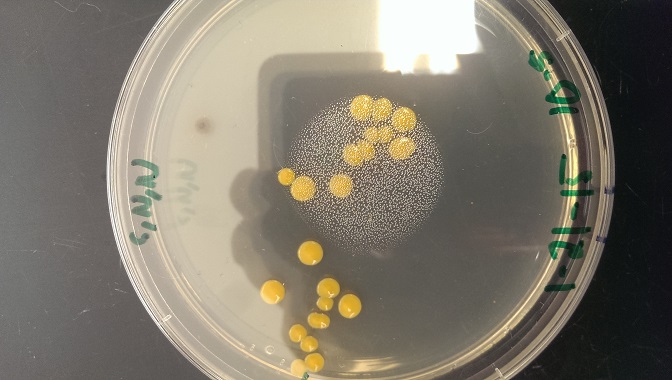
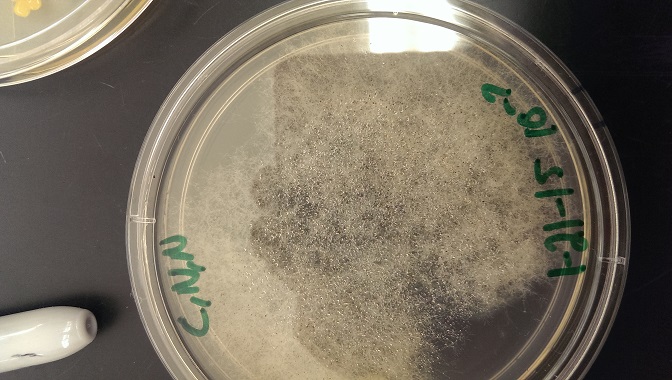
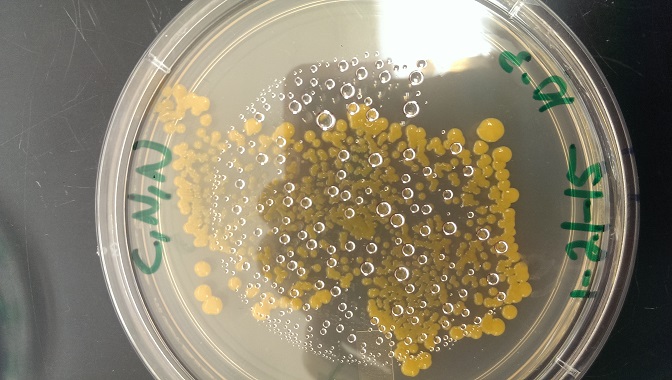
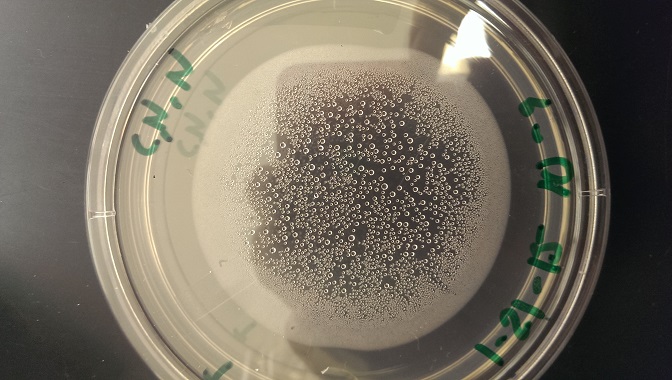
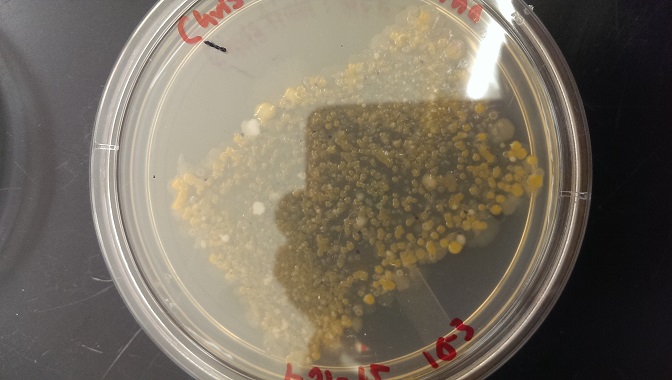
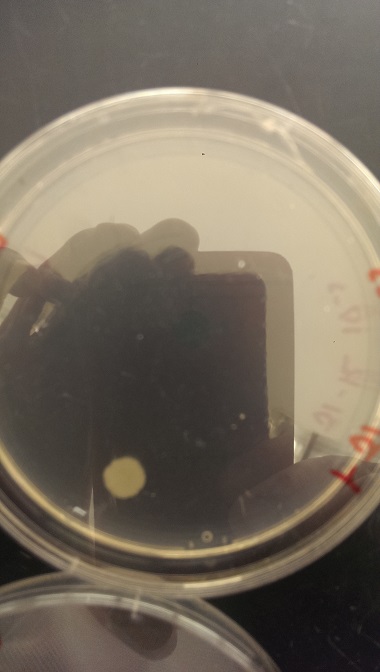
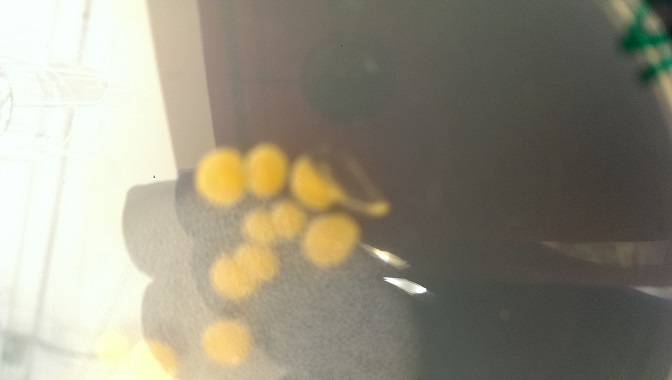
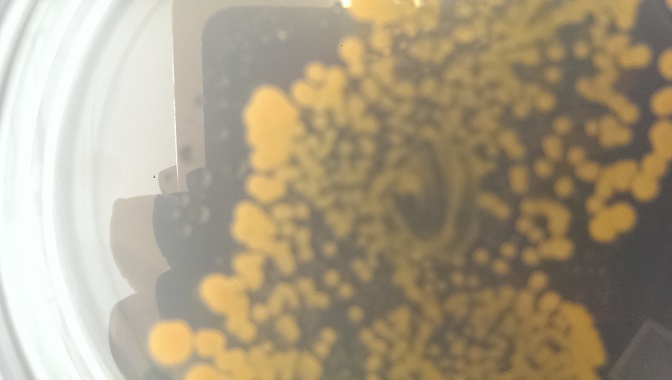
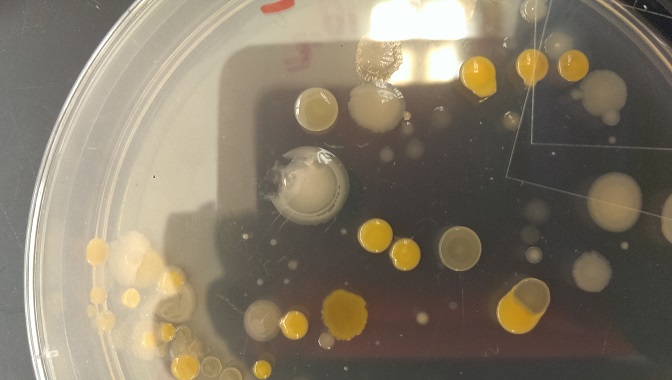
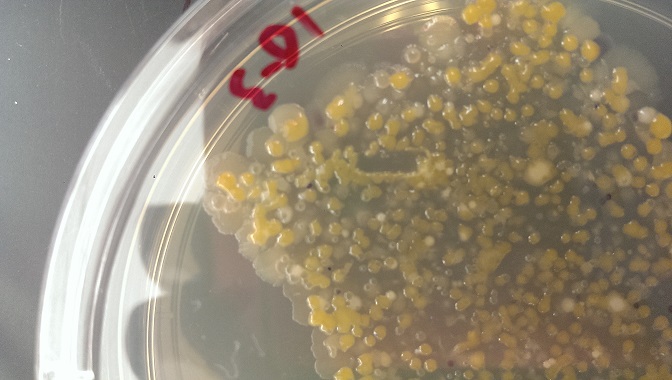

User:Nicholas Carey/Notebook/Biology 210 at AU
=== 3/22/2015- NC ===
Zebrafish
Intro- The purpose of this experiment was to understand the effect on development of rhetinoic acid, better known as vitamin A on embryos. Zebrafish were used because of their convenient size and short life-cycle, a long with their similarities to human embryos. Based on a lab report written prior to the experiment, it was hypothesized that vitamin A would affect the development of the eyes, spinal chord, and possibly cause death in large enough dosages.
Methods- two groups of twenty zebrafish were made, one was exposed to the retinoic acid and the other was a control. At three day intervals, the fish were observed, cataloged, and dead bodies/eggs were removed to prevent moldiness. The fish were also feed a drop of paramecium, water or solution was added as needed to prevent the fish from drying out.
Results-
after the first week the expermient had to be restated to due moldy fish. From the second week to the third week:
Experiment: 15/20 hatched, 9 of those dead, 1-2mm, no observable heartrate, clear with dark patches, smaller eyes than normal, spazy movement, no observable yolk, observable swim bladder, no deviation of mouth
Control:18/20 hatched, 5 of those dead, 1-2mm, non observable heartrate, clear with dark patches, normal eyes, smooth movements, no observable yolk, observable swim bladder, no deviation of mouth
a week after this the fish disappeared from the petri dishes due to unknown causes. Because of this the conductors examined a group from another class doing the same variable.
Experiment: 5/7 alive, 3-4 mm, non observabe heartrate, clear with dark spots, living ones had normal eyes-dead ones had small eyes+bent tails, short choppy movements, no yolk, alive had bladde and dead deformed, deviation of mouth normal
Control: 5/5 alive, 3-4mm, no heart rate observable, transparent with dark spots, normal eyes size, normal movement, no yolk, swim bladder, no deviation of mouth
Conclusion-
Rhetnoic acid appears to affect the eyes, tail, and movement of the zebrafish and eventually causes death. However, it seems if the zebrafish is able to handle the super dosages of vitamin A they remain unaffected. These conclusions derived from far too little data suggest the hypothesis was correct. No idea as to how the fish disappeared. Spillage, sabotage, aliens, or even possibly the chupacabra were all causes for the disappearances. However, given the careless of people and the plenitude of people who had their grubby little hands in that box for our class, Spillage is the most likely answer. That being said, lore states that chupacabras have a ravenous appetite for zebrafish (Dave). At least that is what my friend Dave told me.
References- Dave
2/25/2015- NC
Bacterial Genomic Analysis
Intro- The purpose of this experiemnt was to identify which bacteria the DNA samples were taken from and if the lab results match the observed colonies.
Methods- the PCR of the bacterial sample from the bacterial lab a few weeks ago were sent out to a lab. If each group produced two dark bands for gel electrophoresis, this showed that the DNA in those two samples were viable for testing. The rest of the sample, not run in the gel electrophoresis was then sent to a lab and sequenced. The sequences were then BLASTed. This means they were compared to an archive of known DNA sequences to check for matches. The site used www.ncbi.gov, is an online database containing most of the categorized DNA sequences knownw to science. It brings up similar sequences to the one BLASTed and tells the % similarity, with other facts about the matching sequences.
Data/Observations- My groups sequences were Forward: 27,28 Reverse: 96,97
The sequence for the forward sequences are as follows:
M27 >MB96-Rev_16S_C04.ab1 NNNNNNNNNNNNNNNAGGCAGCTCCTGTTACGGTCACCGACTTCAGGTACCCCAGACTTCCATGGCTTGACGGGCGGTGT GTACAAGGCCCGGGAACGTATTCACCGCGCCATGGCTGATGCGCGATTACTAGCGATTCCAGCTTCATAGAGTCGAGTTG CAGACTCCAATCCGAACTGAGACCGGCTTTCGAGATTTGCATCACTTCGCAGTGTAGCTGCCCTCTGTACCGGCCATTGT ATTACGTGTGTGGCCCAAGGCGTAAGGGCCGTGATGATTTGACGTCATCCCCACCTTCCTCTCTACTTGCGTAGGCAGTC TCACTAGAGTCCCCAACTTAATGATGGCAACTAGTGACAGGGGTTGCGCTCGTTGCAGGACTTAACCTAACACCTCACGG CACGAGCTGACGACAACCATGCAGCACCTTGAAAAATGTCCGAAGAAAAGTCTATTTCTAAACCTGTCATTTCCCATTTA AGCCTTGGTAAGGTTCCTCGCGTATCATCGAATTAAACCACATAATCCACCGCTTGTGCGGGCCCCCGTCAATTCCTTTG AGTTTCAAACTTGCGTTCGTACTCCCCAGGTGGCTAACTTATCACTTTCGCTTAGTCTCTGAAGCTTGCGCTCCAAAAAC GAGTTAGCATCGTTTACGGCGTGGACTACCAGGGTATCTAATCCTGTTCGCTCCCCACGCTTTCGTCCATCAGCGTCAGT TGTTGCTTAGTAACCTGCCTTCGCAATTGGTGTTCTAAGTAATATCTATGCATTTCACCGCTACACTACTTATTCCAGCT ACTTCAACAACACTCAAGACTTGCAGTATCAATGGCAGTTTCACAGTTAAGCTGTGAGATTTCACCACTGACTTACAAAT CCGCCTACGGACCCTTTAAACCCAATAAATCCGGATAACGCTNGCACCCTCCGTATTACCGCGGCTGCTGGCACGGAGTT AGCCGGTGCTTATTCGTATAGTACCTTCAGCTAGATACACGTATCTNGGTTTATCCCTACNCAAAANANTTTACAACCCA TAGGGNCGTCGTCCTTCACGCNGGATGGCTGGATCAGGNTCGCACCATTGTCNNNNTCNCANTGCTGCCTCCCGNNNNNT CTGGTCCGNGTCNTCAGTACCNNNNNNNGGGGATNNNCCCTNNNNCNNN
Accession number: JN572706.1
M28 >MB97-Rev_16S_D04.ab1 NNNNNNNNNNNNNNNNNNNAGGNNCTCNTGTTACGGTCACCGACTTCNNGTACCCCAGACTTCCATGGCTTGACGGGCGG TGTGTACAAGGCCCGGGAACGTATTCACCGCGCCATGGCTGATGCGCGATTACTAGCGATTCCAGCTTCATAGAGTCGAG TTGCAGACTCCAATCCGAACTGAGACCGGCTTTCGAGATTTGCATCACTTCGCAGTGTAGCTGCCCTCTGTACCGGCCAT TGTATTACGTGTGTGGCCCAAGGCGTAAGGGCCGTGATGATTTGACGTCATCCCCACCTTCCTCTCTACTTGCGTAGGCC GTCTCACTAGAGTCCCCAACTTAATGATGGCAACTAGTGACAGGGGTTGCGCTCGTTGCAGGACTTAACCTAACACCTCA CGGCACGAGCTGACGACGACCATGCAGCACCTTGAAAAATGTCCGAAGAAAAGTCTATTTCTAAACCTGTCATTTCCCAT TTAAGCCTTGGTAAGGTTCCTCGCGTATCANCGAATTAAACCACATAATCCACCGCTTGTGCGGGCCCCCGTCAATTCCT TTGAGTTTCAAACTTGCGTTCGTACTCCCCAGGTGGCTAACTTATCACTTTCGCTTAGTCTCTGAAGCTTGCGCTCCAAA AACGAGTTAGCATCGTTTACGGCGTGGACTACCAGGGTATCTAATCCTGTTCGCTCCCCACGCTTTCGTCCATCAGCGTC AGTTGTTGCTTAGTAACCTGCCTTCGCAATTGGTGTTCTAAGTAATATCTATGCATTTCACCGCTACACTACTTATTCCA GCTACTTCAACAACACTCAAGACTTGCAGTATCAATGGCAGTTTCACAGTTAAGCTGTGAGATTTCACCACTGACTTACA AATCCGCCTACNGACCCTTTAAACCCAATAAATNCNGGATAACGCTNGCACCCTCCGTATTACCGCGGCTGCTGGCACGG AGTTAGCCNGGTGCTNATTCGTATAGTACCTTCAGCTAGATNCACGTATCNNGGTTTATCCCTACACAAAGAGTTTANNN CCANANNNNCGTCNTNNNCACGCGGATGCTGNTCNGNTCGCACCNTGTCANATTCNCNNTGCTNCCTCCGTNNNNNNCNG GTCCNNGNCTCAGNNCNGNNNNGGGNNNCNCCCTCNTNNNNNCCCNANNNANNN
Accession number: HQ289892.1
Both sequences are from the Bacteria Chryseobacterium
Discussion- The bacterial samples were taken from the T and N 1x10E-3 petri dishes. Although the two samples appeared to be different in lab, upon closer inspection compared to known colonies of Chryseobacterium (microbewiki, 2015) it appears both were in fact colonies of that bacterial family and they just looked slightly different. Mistakes were made in the observation of the different slides. For one sample the bacteria were correctly identified as gram negative, for the other they were mistaken for gram positive, likely due to the staining of the slide itself rather than the bacteria. The bacteria were mistaken for cocci bacteria in both samples when they were in realty rod shaped. Based on this I would say the match is actually correct for both samples but some observation errors were made by those recording the shape and coloring of the samples under the microscope.
References- https://microbewiki.kenyon.edu/index.php/Chryseobacterium_indologenes 3/3/2015
2/17/2015- NC
Invertebrates and Vertebrates from Manicured Grassland
Intro- Invertebrates are animals that lack a backbone. They express either bilateral or radial symmetry, depending on their complexity. Most invertebrates present in the soil are arthropods, a phylum that includes insects and arachnids. However, worms are also very common in the soil. Vertebrates are animals that do poses a backbone and also come in many forms although they generally do not exist within the soil. All invertebrates and vertebrates are important members of their respective ecosystems. It was predicted that a diverse groups of invertebrates would be observed.
Materials and Methods- The lab was carried out as outlined by the manual (Bentley, 2015). This includes observing the movement of Acoelomates, Psedocoelomates, and coelomates, arthropods were studied. After this invertebrates from the Berlese Funnel were observed and identified using the website www.hope.edu/academic/biology/leaflitterarthropods/ . Then, the vertebrates that may possibly live or pass through the transect were considered.
Data/observations- Planaria move very similar to sheet of paper, very flowing in nature.
Nematodes move with a set of wriggling contractions.
Coelmates move in a rhythmic set of contractions.
Stripped Springtail- collembola- 3mm long- 1 found in sample
Termite- Isoptera 1mm long- 1 in sample
Nematoda- 3mm long- 2 found in sample
Annelid- .5mm long- 1 found in sample
Silverfish- Thysanura- 6mm long- 1 found in sample
Range for sizes- 5.5mm Largest-Silverfish Smallest-Annelid Most common organism- nematode
Vertebrates that could also live in the transect-
Eastern American Toad- Chordata Amphibia Anura Bufonidae Anaxyrus americanus- the toad could consume the invertebrates and hibernate in the soil over winter
Carolina Chickadee- Chordata Aves Passeriformes Paridae Poecile carolinesis- the tree outside the transect gives the chickadee a excellent look out post, it may also venture into the transect to forage for insects
Bluejay- Chordata Aves Passiformes Corivadae Cyanocitta cristata- the transect provides invertebrates for the bluejay to consume, also the tree is present for perching
White Footed Mouse- Chordata Mammalia Rodentia Cricentidae Peromyscus leucopus- provides a place for the mouse to burrow, also has food resources although not ideal
Robin- Chordata Aves Passiformes Turdidae Turdus migratorius- transect provides insects and invertebrates for consumption, nearby tree for perching
an estimate of the foodweb for the ecosystem
Conclusions- Plinaria showed a flowing motion which results from its mesoderm contracting and causes it to glide. Nematodes use four groupings of muscles to force fluid against their dermis and produce their wriggling motion, Coelates extend their body outward in segments, and after securing it contract their muscles to pull themselves forward. A community is defined as all of the living organisms in a given area, the food web clearly shows this by the different species present and their interactions. The carrying capacity of an ecosystem is the maximum number of a specific species that it can support. Obviously smaller organisms like bacteria or paramecium can exist in much higher numbers due to their lesser requirement of resources per individual versus a plant or animal. Trophic levels describes a species' place on the food web. For example grass produces energy from the sun and does not need to consume anything, therefore it is a producer. Robins consume the invertebrates that eat the plants, therefore they are secondary consumers. Bacteria and paramecium consume the decaying remains of plants and are therefore decomposers. A great deal of diversity was not found in the invertebrates of the transect, silverfish and springtails are closely related with the termite and the worms being the more novel species observed. So while diverse, there was not as much diversity as expected. Also the five invertebrates recorded were the only ones observed. It was expected that there would be a larger number or total specimens.
References-
Bentley, Meg. 2015. A Laboratory Manual to Accompany: General Biology II. American University: Washington, DC. Pg.45-49
2/10/2015- NC
Plant Matter from Manicured Grassland and Fungal Observations
Intro- Plants are the producers of energy for almost all ecosystems. Without plants, all other forms of complex life would cease to exist. Plants can be identified and classified based on many different categories. Vascular vs. Non vascular, angiosperm vs. gymnosperm, monocot vs. dicot, these are just some examples of how plants are compared to one another. One can also investigate structures such as thorns, petals, cuticles, taproots,and other uniquely evolved devices. This lab aims to familiarize the practitioner with some of these methods for identifying plants along with their classification.
Materials and Methods- Five different plant specimens were taken from the transect for observation and rough classification based upon these observations. The vascular nature of the plants was noted, as were any special structures. The plant's method of reproduction were then studied along with any seeds found. After this samples of fungi presented by the instructor were observed. Also, decaying plant matter was collected and placed in a funnel next to a light source which lead to preservative. This set up was intended to capture invertebrates present in the debris.
Data/Observations-
All plants observed seemed to be angiosperms
Bulb- 6 located in NW corner of transect between roses and cut bush, 16cm in diameter, monocot, likely genus Lilium, reproduces through seeds
small dark folded leaf emerging from bulb
Cut bush- one located in far NW corner of transect, 18cm long, hollow stem, appears to be monocot, unknown genus, likely reproduces through seeds
no visible leaves
Grass- covers roughly 2/3 of transect (eastern and northern areas primarily), 4cm long, monocot, likely Festuca genus, seeds and rhizome used to reproduce
single blades of parallel veins extending from roots
Rose- 6 located along western edge of transect, 15cm long, dicot, Rosa genus thorns, sepal, peduncle, and receptacle are specialized structures, reproduces with seeds
waxy red-green leaves extending from stem
Tall Grass- 20 located between and around rose bushes, 24cm long, monocot, unknown genus, likely reproduces through seeds and rhizome
multiple leaf blades with parallel veins from a single root structure
No actual seeds were found in transect- evidence of flowers present on rose bushes
Sporangia are reproductive cells of fungi, used to produces spores which are then somehow spread elsewhere usually through the air
Gills or lamella of fungi visible, used in production of basidia which are the sexual cells of certain fungi
Conclusion-
The transect has a very limited diversity of plant life. It it primarily lawn grass with a small number of a few other species also present. There were no observable fungi within the transect. The experiment was succesful in it goal to bring those partaking into the world of plant adaptation and taximony.
References- Bentley, Meg. 2015. A Laboratory Manual to Accompany: General Biology II. American University: Washington, DC. Pg.34-43
2/4/2015- NC
Bacterial Identification and DNA Sequences from Transect #5
Intro- Prokaryotes are the most expansive, numerous, and resilient forms of life on earth. They come from two domains- Archaea and Bacteria. Bacteria are what we normally associate with prokaryotes. Archaea tend to live in very extreme environments around the world. It is not likely that Archaea will be present on the agar plates as the temperature was not either very high or low. Nor was any other factor pushed to an extreme- conditions that Archaea prefer. In this experiment the jar represents an ecosystem. Like actual ecosystems, the conditions within the jar changed over time and is dynamic. It is likely that the nutrients from the organic matter leached into the water while oxygen left the water since it was stagnant. Also, biotic factors within the environment may have released certain chemicals into the ecosystem. This cn drastically affect the types of life present wit the ecosystem.
Materials and Methods- First the culture was observed and analyzed. Then the plates that were inoculated last week were observed and the number of bacterial colonies present was recorded. After this a wet mount for two of the samples was made to observe motility under a microscope. A gram stain was also produced for 4 different samples as outlined by the lab manual (Bentley, 2015). These were also observed under a microscope. These same 4 samples were used to create PCR sequences for next week's experiment.
Data/Observations-
Dilution Agar Type Colonies Conversion factor Colonies/mL
10-3 nutrient 200 103 200,000
10-5 nutrient 57 105 5,700,000
10-7 nutrient 1 107 10,000,000
10-9 nutrient 0 109 0
10-3 Tet 150 103 150,000
10-5 Tet 22 105 2,200,000
10-7 Tet 2 107 20,000,000
10-9 Tet 0 109 0
Label Plate Description Description Gram +/- 1 N 10-3 Irreg., undulate, rasiedorange Not motile, Clumps/chains, cocci + 2 T 10-5 Circular entire convex orange Not motile, clumps/chains. Cocci - 3 N 10-5 Convex circled circular white Not motile, random, barilla burgdarferi + 4 T 10-3 Irregular undulate raised orange not motile, clumps/chains, cocci -
The culture showed no change in smell as it was still neutral. The water got significantly murkier and brownish in nature
Tetracycline inhibits protein synthesis by disrupting the translation process of RNA into protein (Chopra). It was once effective against many gram positive and negative bacteria but now is much less effective (tertracyline).
Conclusions No signs of archaea were found, confirming the hypothesis proposed. The hypothesis regarding the relation between factors over time and the outward appearances of the Hay infusion could not be tested as protists were examined last week. If bacteria were observed then, a comparison could possibly have been made in order to deduce something.Tetracycline appears to be a rather ineffective antibiotic as it only limits bacterial grown and cannot stop it.It seemed to cut the rate of bacterial colonies in about half. Tetracycline appears to be particularly inefficient at fighting gram negative bacteria, allowing them to populate the sample
References- Bentley, Meg. 2015. A Laboratory Manual to Accompany: General Biology II. American University: Washington, DC. Pg.16-17 Tetracycline: MedlinePlus Drug Information. (2010, January 9). Retrieved February 4, 2015, from http://www.nlm.nih.gov/medlineplus/druginfo/meds/a682098.html Chopra, I., & Roberts, M. (n.d.). Tetracycline Antibiotics: Mode of Action, Applications, Molecular Biology, and Epidemiology of Bacterial Resistance. Retrieved February 4, 2015, from http://www.ncbi.nlm.nih.gov/pmc/articles/PMC99026/
1/28/2015- NC
A Study of the Protozoa and Algae Present in Transect #5
Intro- Eukaryotes and Prokaryotes form the two main divisions of life forms. Eukaryotes are cells that contain nuclei and can range from single celled to multicellular organisms. Single celled Eukaryotes generally fall into one of two groups: photosynthetic algae or heterotrophic protozoa. This experiment attempts to identify some of the microscopic eukaryotes present in our ecosystem and the niches they occupy.
Materials and Methods- Samples were taken from two distinct niches of the culture, one from the top layer and the other from the bottom sediment. Then each distinct sample was put on a slide with proto-slow for observation. From each of the two slides three different species of organism were identified for a total of six different organisms. These organism were identified using a dichotomous key which was provided in class. After this the entire culture was shaken up to create uniform distribution.100 uLs of this solution was added to 10 mLs of broth. Then 100 uLs of this second solution was added to another 10 mLs of broth. This process was repeated two more times resulting in 4 solutions of varying concentration. The following solutions had concentrations of 1:100, 1:10,000, 1:1,000,000, and 1:100,000,000. 100 uLs of each solution was then platted onto labelled normal agar plates, and another 100 uLs of each solution was platted onto labelled tetracycline agar plates. Plates were inoculated using a glass spreader dipped in ethanol and passed through flame. And then incubated for next week’s lab.
Data/Observations-
The culture smelled of dirt, slightly musky in nature. The aromawas not offensive or pungent. There appeared to be a mold on top which was primarily brown with small white specs dotted throughout. All the organisms observed were motile protozoa that utilized cilia to move, as a result they do not photosynthesize.
Conclusions- Euplotes are capable of reproduction, consist of a cell, respond to their environment, engage in anabolic and catabolic reactions, grow, and regulate homeostasis. If the Hay Infusion Culture was left for two more months the amount of anaerobic bacteria would likely increase as oxygen becomes more scarce in the jar. Also, the amount of bacteria decomposing the organic matter would likely decrease as it was used up. The selective pressures that could affect the community would be interactions between species. Some species release toxins to disrupt other species in order to promote their own growth. These different fluctuations of biotic and abiotic factors create unique niches within the culture which allow for certain species to flourish in some areas over others. For example those organisms by plant matter are likely to be decomposers of the plant matter and likely anaerobic in nature since the plants release CO2 as they decompose, amongst toxic substances like ammonia.
References- Bentley, Meg. 2015. A Laboratory Manual to Accompany: General Biology II. American University: Washington, DC. Pg.16-17
1/23/2015- NC
An intro to Biological Life at AU- Assignment of Transect
Intro- Ecology is the study of how different factors within an environment interact (Bentley, 2015). In order to better understand these interactions and the diversity of life, a transect will be studied. A transect is a small patch of land, that works as a manageable ecosystem to study rather than studying a huge area. The purpose of this experiment is to familiarize each group with their transect. This familiarization will likely be useful in the upcoming experiment centered on each group's transect.
Materials and Methods- The class was broken up into groups and each group was lead to their respective transect. Each group also was given a container for a soil sample. Each group member had to draw and label the transect, being sure to account for all abiotic and biotic environmental factors. After the transect was properly diagrammed, a sample was taken from the soil that best represented the make up of the transect. This sample of soil was then used to make a Hay Infusion Culture for another experiment. 10 to 12 grams of the soil was placed in a labelled jar with 500 mLs of water. Then .01g of dried milk was added to the jar and it was gently mixed for 10 seconds. After this the top of the jar was removed and it was left out until the next lab session. All of this was carried out in accordance with the provided lab manual (Bentley, 2015).
Data/observations-
The transect was located immediately in front of the main entrance to Hurst Hall on the Eric Friedheim Quadrangle. It was mostly cut lawn grass with a significant portion consisting of mulch and soil with planted bushes. Abiotic components included: the pillar of a monument on the quadrangle, he soil/mulch mixture of the bushes, soil underneath the grass. The biotic factors included: grass, a tall grass-like plant, flowering bushes, and a dense bush.
Conclusions-
It was clear that the assigned transect was the "Manicured Grassland" transect. A better understanding of the transect was acquired and this may prove useful in future endeavors. The Hay Culture Infusion for next lab seemed to be properly mixed and will hopefully lead to promising results in a week. Hopefully these next lab's results increase the data derived from he transect and also contribute to the understanding of ecosystems on the whole.
References- Bentley, Meg. 2015. A Laboratory Manual to Accompany: General Biology II. American University: Washington, DC. Pg.16-17
TEST Nick Carey
Bold texttest AP